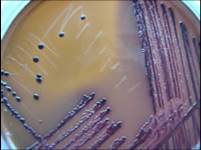

海博微信公众号
海博微信公众号
 海博天猫旗舰店
海博天猫旗舰店


 海博微信公众号
海博微信公众号
 海博天猫旗舰店
海博天猫旗舰店




伊红美蓝琼脂(EMB琼脂)(g/L)
蛋白胨10.0
乳糖10.0
伊红γ0.4
美蓝0.065
磷酸氢二钾(K2HPO4)2.0
琼脂15.0
pH 7.1±0.2 25℃
蛋白胨提供细菌生长发育所需的氮源、维生素和氨基酸,乳糖提供发酵所需的碳源,磷酸氢二钾维持缓冲体系,伊红Y和美蓝抑制绝大部分革兰氏阳性菌的生长。伊红Y为酸性染料,美蓝为碱性染料,琼脂是凝固剂。大肠杆菌和大肠菌群上发酵乳糖产酸时,细菌带正电荷,所以染上伊红(红色),再与美蓝结合形成紫黑色菌落,大部分有金属光泽。
BGLB肉汤

上一篇:沙门氏菌的在培养基上的特征
下一篇:螺旋平板法-接种方法



